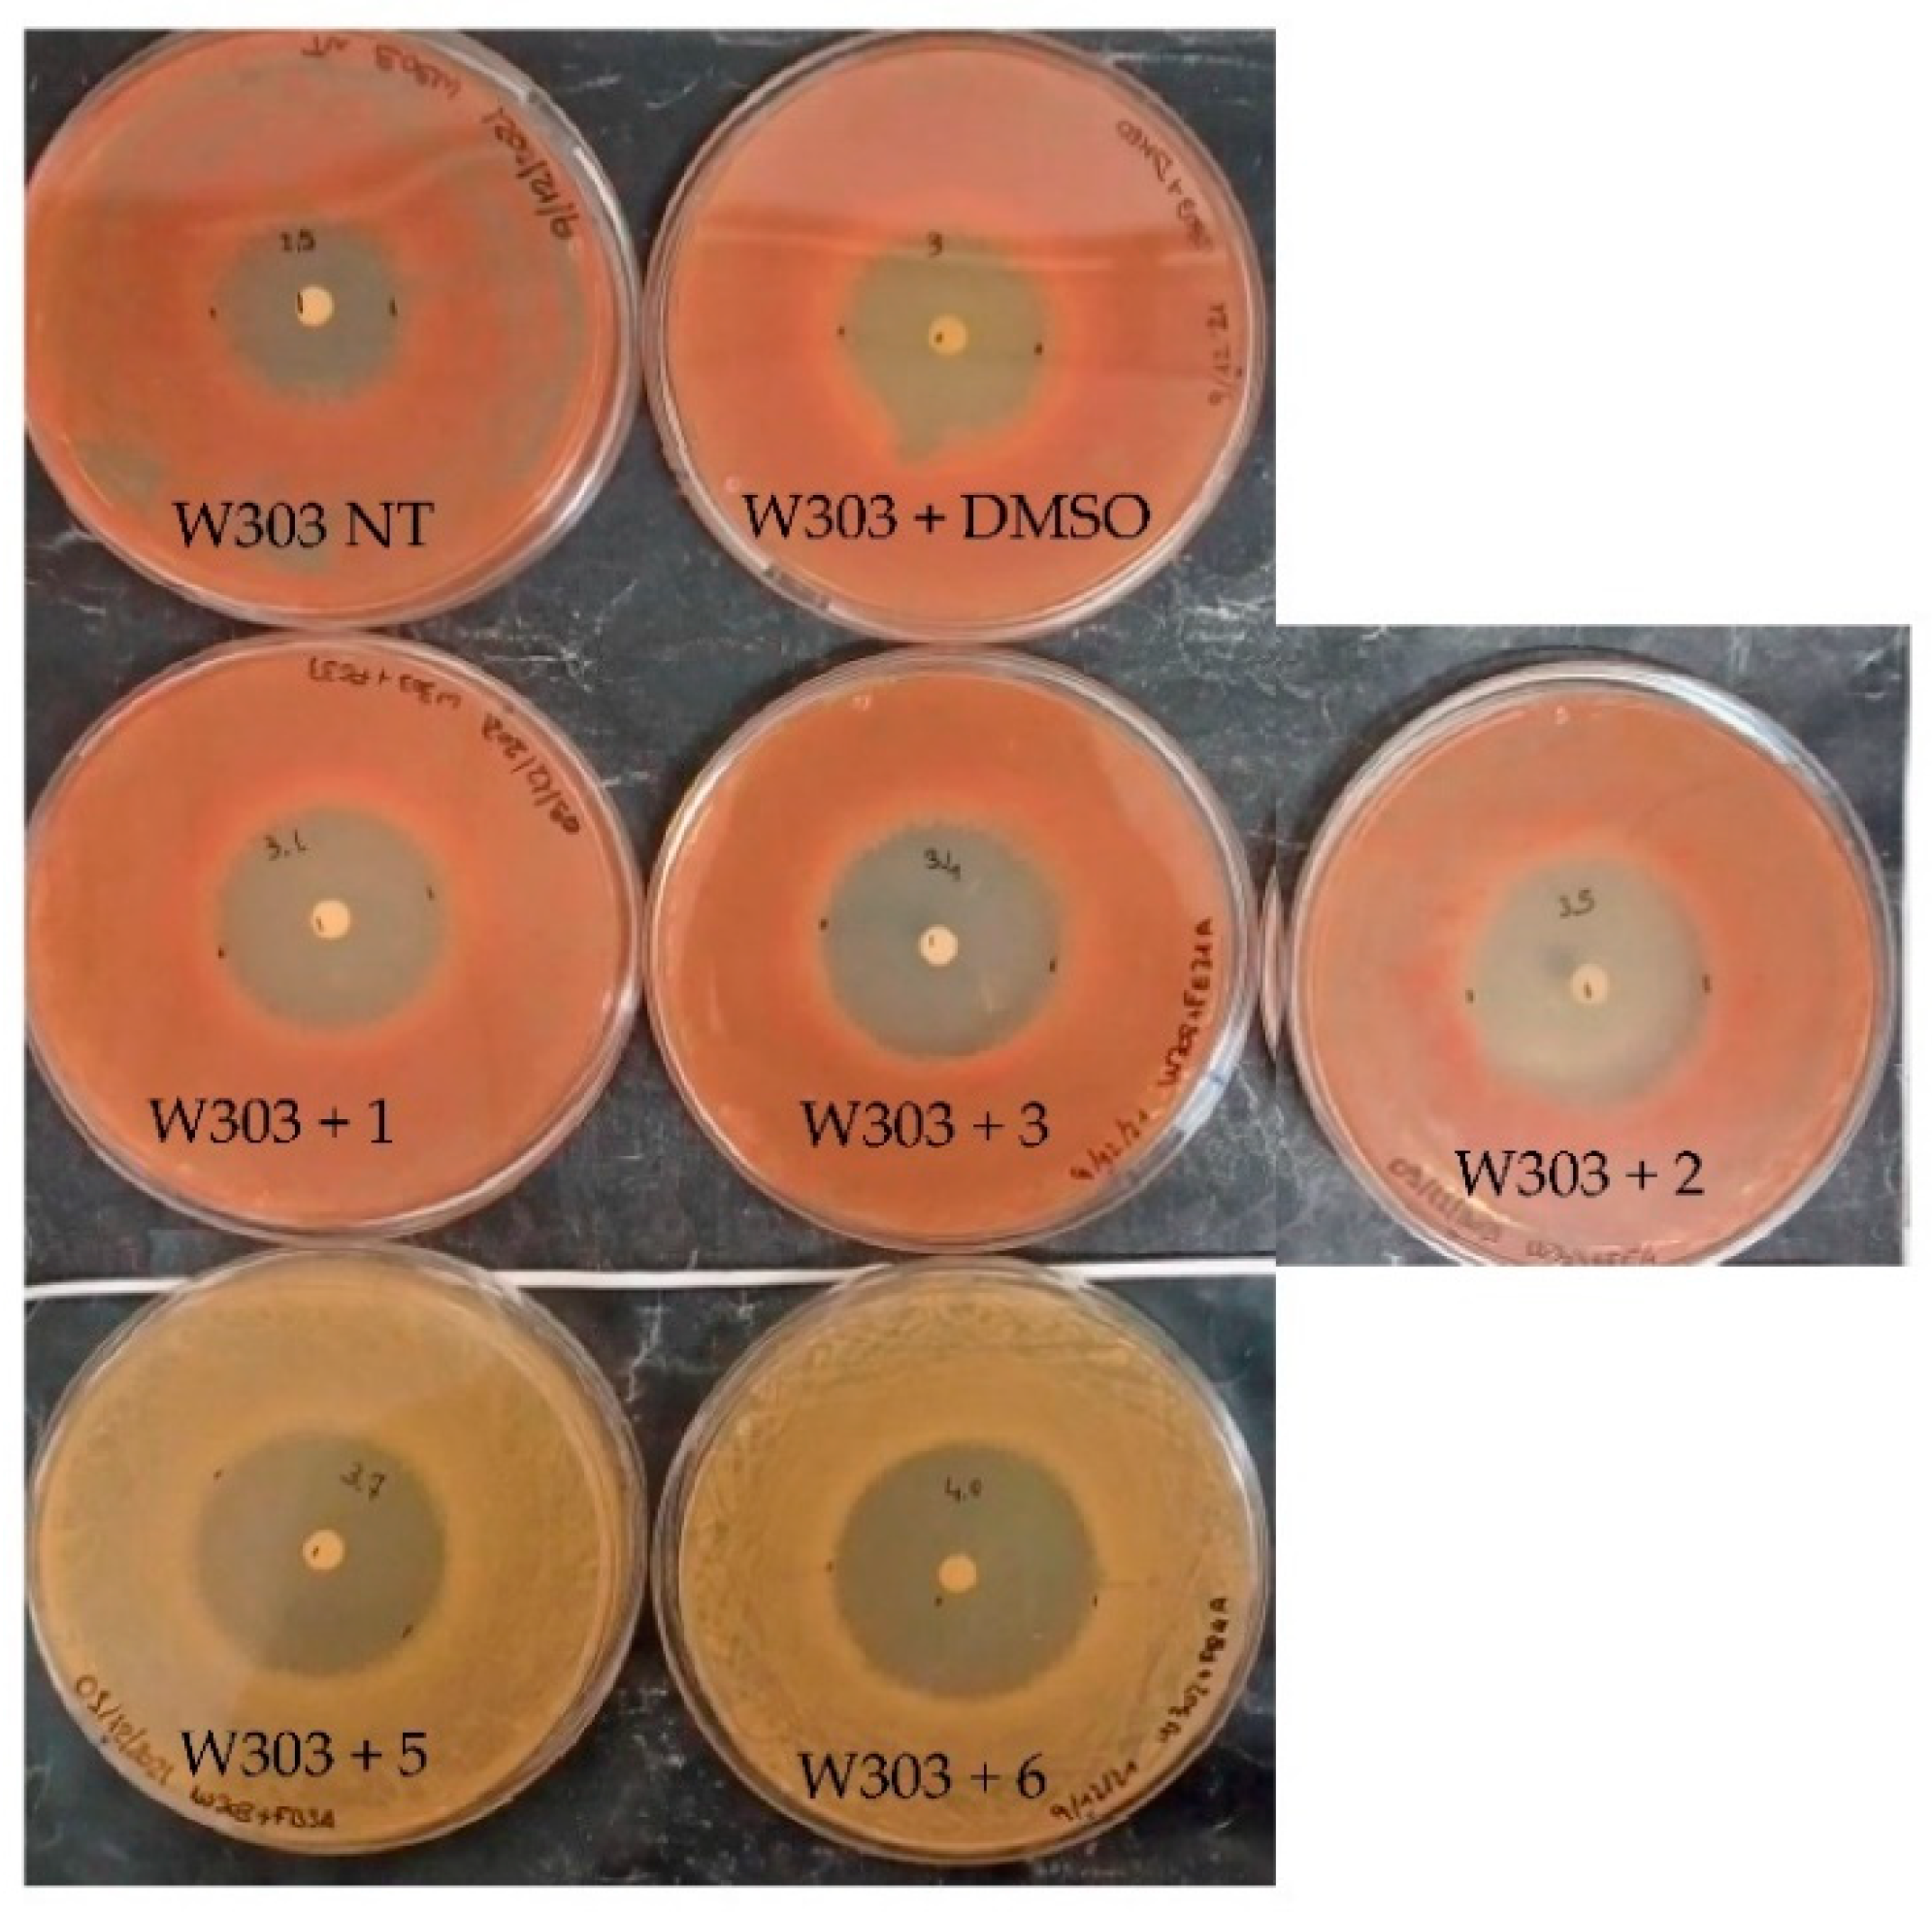
Molecules 27 05234 g003 Molecules 27 05234 g003

Antifungal and Cytotoxic Activity of Diterpenes and Bisnorsesquiterpenoides from the Latex of Euphorbia resinifera Berg
Abstract
1. Introduction
2. Results
2.1. Chemical Results
2.2. Biological Results
2.2.1. Evaluation of the Effect of Compounds on the Yeast S. cerevisiae
2.2.2. Evaluation of the Compounds’ Antifungal Effect
2.2.3. Evaluation of the Compounds’ Cytotoxicity
2.2.4. Evaluation of Mitochondrial ROS Formation in Human Cell Lines
3. Discussion
4. Materials and Methods
4.1. General Experimental Procedures
4.2. Plant Material
4.3. Extraction and Isolation
4.4. Physical and Spectroscopic Data of Compounds 1–9
4.4.1. 12-Deoxyphorbol-13-angelate-20-acetate (1)
4.4.2. 12-Deoxyphorbol-13-isobutyrate-20-acetate (2)
4.4.3. 7-p-Metoxyphenylacetate-3,8,12-triacetate ingol (3)
4.4.4. Resiniferatoxin (4)
4.4.5. Deglucosyl Euphorbioside A (5)
4.4.6. Euphorbioside A (6)
4.4.7. Catechol (7)
4.4.8. Protocatechuic Acid (8)
4.4.9. 3,4-Dihydroxyphenylacetic Acid (9)
4.5. Fungal Culture
4.6. Antifungal Assay
4.7. Cell Culture
4.8. Cytotoxicity Assay
4.9. Mitochondrial ROS Formation in Human Cell Lines
5. Conclusions
Supplementary Materials
Author Contributions
Funding
Institutional Review Board Statement
Informed Consent Statement
Data Availability Statement
Acknowledgments
Conflicts of Interest
Sample Availability
References
- Bray, F.; Ferlay, J.; Soerjomataram, I.; Siegel, R.I.; Torre, L.A.; Jemal, A. Global cancer statistics 2018: GLOBOCAN estimates of incidence and mortality worldwide for 36 cancers in 185 countries. CA Cancer J. Clin. 2018, 68, 394–424. [Google Scholar] [CrossRef] [PubMed]
- Torres, H.A.; Rivero, G.A.; Lewis, R.E.; Hachem, R.; Raad, I.; Kontoyiannis, D.P. Aspergillosis caused by non-fumigatus Aspergillus species: Risk factors and in vitro susceptibility compared with Aspergillus fumigatus. Diagn. Microbiol. Infect. Dis. 2003, 46, 25–28. [Google Scholar] [CrossRef]
- Bérubé, G. How to utilize academic research efforts in cancer drug discovery. Expert Opin. Drug Discov. 2019, 14, 331–334. [Google Scholar] [CrossRef] [PubMed]
- Nicola, A.M.; Albuquerque, P.; Paes, H.C.; Fernandes, L.; Costa, F.F.; Kioshima, E.S.; Abadio, A.K.R.; Bocca, A.L.; Felipe, M.S. Antifungal drugs: New insights in research & development. Pharmacol. Ther. 2018, 195, 21–38. [Google Scholar] [CrossRef] [PubMed]
- Ernst, M.; Saslis-Lagoudakis, C.H.; Grace, O.M.; Nilsson, N.; Toft Simonsen, H.; Horn, J.W.; Rønsted, N. Evolutionary prediction of medicinal properties in the genus Euphorbia L. Sci. Rep. 2016, 6, 30531. [Google Scholar] [CrossRef] [PubMed]
- Newman, D.J.; Cragg, G.M. Natural products as sources of new drugs over the last 25 years. J. Nat. Prod. 2007, 70, 461–477. [Google Scholar] [CrossRef] [PubMed]
- Singla, A.; Pathak, K. Phytoconstituents of Euphorbia species. Fitoterapia 1990, 41, 483–516. [Google Scholar]
- Fattorusso, E.; Lanzotti, V.; Taglialatela-Scafati, O.; Tron, G.C.; Appendino, G. Bisnorsesquiterpenoids from Euphorbia resinifera Berg. and an Expeditious Procedure to Obtain Resiniferatoxin from Its Fresh Latex. Eur. J. Org. Chem. 2002, 2002, 71–78. [Google Scholar] [CrossRef]
- Hergenhahn, M.; Kusumoto, S.; Hecker, E. Diterpene esters from ‘Euphorbium’ and their irritant and cocarcinogenic activity. Experientia 1974, 30, 1438–1440. [Google Scholar] [CrossRef]
- Hergenhahn, M.; Adolf, W.; Hecker, E. Resiniferatoxin and other esters of novel polyfuncticnal diterpenes from Euphorbia resinifera and unispina. Tetrahedron Lett. 1975, 16, 1595–1598. [Google Scholar] [CrossRef]
- Zhao, N.D.; Ding, X.; Song, Y.; Yang, D.Q.; Yu, H.L.; Adelakun, T.A.; Qian, W.D.; Zhang, Y.; Di, Y.T.; Gao, F.; et al. Identification of Ingol and Rhamnofolane Diterpenoids from Euphorbia resinifera and Their Abilities to Induce Lysosomal Biosynthesis. J. Nat. Prod. 2018, 81, 1209–1218. [Google Scholar] [CrossRef]
- Wang, S.Y.; Li, G.Y.; Zhang, K.; Wang, H.Y.; Liang, H.G.; Huang, C.; Huang, J.; Wang, J.H.; Yang, B.F. New ingol-type diterpenes from the latex of Euphorbia resinifera. J. Asian Nat. Prod. Res. 2019, 21, 1075–1082. [Google Scholar] [CrossRef]
- Ponsinet, G.; Ourisson, G. Aspects particuliers de la biosynthèse des triterpènes dans le latex d’Euphorbia. Phytochemistry 1968, 7, 757–764. [Google Scholar] [CrossRef]
- Mazoir, N.; Benharref, A.; Bailén, M.; Reina, M.; Gonzàlez-Coloma, A. Bioactive triterpene derivatives from latex of two Euphorbia species. Phytochemistry 2008, 69, 1328–1338. [Google Scholar] [CrossRef]
- Wang, S.; Liang, H.; Zhao, Y.; Wang, G.; Yao, H.; Kasimu, R.; Wu, Z.; Li, Y.; Huang, J.; Wang, J. New triterpenoids from the latex of Euphorbia resinifera Berg. Fitoterapia 2016, 108, 33–40. [Google Scholar] [CrossRef]
- Boe, J.E.; Winsnes, R.; Nordal, A.; Bernatek, E. New constituents of Euphorbia resinifera Berg. Acta Chem. Scand. 1969, 23, 3609. [Google Scholar] [CrossRef][Green Version]
- Fatope, M.O.; Zeng, L.; Ohayaga, J.E.; Shi, G.; McLaughlin, J.L. Selectively Cytotoxic Diterpenes from Euphorbia poisonii. J. Med. Chem. 1996, 39, 1005. [Google Scholar] [CrossRef]
- Ragasa, C.Y.; Cornelio, K.B. Triterpenes from Euphorbia hirta and their cytotoxicity. J. Nat. Med. 2013, 11, 528–533. [Google Scholar] [CrossRef]
- Wang, S.Y.; Huang, C.; Sun, R.K.; Lu, L.N.; Liang, H.G.; Gao, L.; Huang, J.; Wang, J.H.; Yang, B.F. New tirucallane triterpenoids from the dried latex of Euphorbia resinifera. Phytochem. Lett. 2019, 29, 220–224. [Google Scholar] [CrossRef]
- Geribaldi-Doldán, N.; Flores-Giubi, E.; Murillo-Carretero, M.; García-Bernal, F.; Carrasco, M.; Macías-Sánchez, A.; Sánchez, J.; Domínguez-Riscart, J.; Verástegui, C.; Hernández-Galán, R.; et al. 12-Deoxyphorbols Promote Adult Neurogenesis by Inducing Neural Progenitor Cell Proliferation via PKC Activation. Int. J. Neuropsychopharmacol. 2015, 19, pyv085. [Google Scholar] [CrossRef]
- Kim, C.H.; Lim, S.J.; Gollapaudi, S.; Gupta, S. Role of Protein Kinase C Isozymes in Activation of Human Immunodeficiency Virus Type 1 in Chronically Infected Promonocytic Cells: Evidence Against a Role of PKCβ1. Biochem. Biophys. Res. Commun. 1994, 199, 292–297. [Google Scholar] [CrossRef]
- Daoubi, M.; Marquez, N.; Mazoir, N.; Benharref, A.; Hernández-Galán, R.; Munozc, E.; Isidro, G.; Colladoa, I.G. Isolation of new phenylacetylingol derivatives that reactivate HIV-1 latency and a novel spirotriterpenoid from Euphorbia officinarum latex. Bioorg. Med. Chem. 2007, 15, 4577–4584. [Google Scholar] [CrossRef]
- Farah, H.; Echchahad, A.; Lamiri, A. Semi-synthesis and antimicrobial activities of some new euphorbioside derivatives. Int. J. Chem. Tech. Res. 2014, 6, 763–767. [Google Scholar]
- Mazoir, N.; Benharref, A.; Bailén, M.; Reina, M.; González-Coloma, A.; Martínez-Díaz, R.A. Antileishmanial and antitrypanosomal activity of triterpene derivatives from latex of two Euphorbia species. Z. Nat. C J. Biosci. 2011, 66, 360–366. [Google Scholar] [CrossRef]
- Vasas, A.; Hohmann, J. Euphorbia diterpenes: Isolation, structure, biological activity, and synthesis (2008–2012). Chem. Rev. 2014, 114, 8579–8612. [Google Scholar] [CrossRef]
- Wang, H.B.; Wang, X.Y.; Liu, L.P.; Qin, G.W.; Kang, T.G. Tigliane Diterpenoids from the Euphorbiaceae and Thymelaeaceae Families. Chem. Rev. 2015, 115, 2975–3011. [Google Scholar] [CrossRef]
- Hashimoto, S.; Katoh, S.I.; Kato, T.; Urabe, D.; Inoue, M. Total Synthesis of Resiniferatoxin Enabled by Radical-Mediated Three-Component Coupling and 7-endo Cyclization. J. Am. Chem. Soc. 2017, 139, 16420–16529. [Google Scholar] [CrossRef]
- Allred, T.K.; Manoni, F.; Harran, P.G. Exploring the Boundaries of “Practical”: De Novo Syntheses of Complex Natural Product-Based Drug Candidates. Chem. Rev. 2017, 117, 11994–12051. [Google Scholar] [CrossRef]
- Wender, P.A.; Jesudason, C.D.; Nakahira, H.; Tamura, N.; Tebbe, A.L.; Ueno, Y. The First Synthesis of a Daphnane Diterpene: The Enantiocontrolled Total Synthesis of (+)-Resinifera toxin. J. Am. Chem. Soc. 1997, 119, 12976–12977. [Google Scholar] [CrossRef]
- Cruz, F.; Guimaraes, M.; Silva, C.; Reis, M. Suppression of bladder hyperreflexia by intravesical resinifera toxin. Lancet 1997, 350, 640–641. [Google Scholar] [CrossRef]
- Brederson, J.D.; Kym, P.R.; Szallasi, A. Targeting TRP channels for pain relief. Eur. J. Pharmacol. 2013, 716, 61. [Google Scholar] [CrossRef] [PubMed]
- Brown, D.C. Resiniferatoxin: The Evolution of the “Molecular Scalpel” for Chronic Pain Relief. Pharmaceuticals 2016, 9, 47. [Google Scholar] [CrossRef] [PubMed]
- Szallazi, A.; Blumberg, P.M. Resiniferatoxin, a phorbol-related diterpene, acts as an ultrapotent analog of capsaicin, the irritant constituent in red pepper. Neuroscience 1989, 30, 515–520. [Google Scholar] [CrossRef]
- Appendino, G.; Szallasi, A. Euphorbium: Modern research on its active principle, resiniferatoxin, revives an ancient medicine. Life Sci. 1997, 60, 681–696. [Google Scholar] [CrossRef]
- Popplewell, W.L.; Marais, E.A.; Brand, L.; Harvey, B.H.; Davies-Coleman, M.T. Euphorbias of South Africa: Two New Phorbol Esters from Euphorbia Bothae. S. Afr. J. Chem. 2010, 63, 175–179. [Google Scholar]
- Adolf, W.; Sorg, B.; Hergenhahn, M.; Hecker, E. Structure-activity relations of polyfunctional diterpenes of the daphnane type. I. revised structure for resiniferatoxin and structure-activity relations of resiniferonol and some of its esters. J. Nat. Prod. 1982, 45, 347. [Google Scholar] [CrossRef]
- Huang, S.; Zhang, C.P.; Li, G.; Sun, Y.Y.; Wang, K.; Hu, F.L. Identification of Catechol as a New Marker for Detecting Propolis Adulteration. Molecules 2014, 19, 10208–10217. [Google Scholar] [CrossRef]
- Gutzeit, D.; Wray, V.; Winterhalter, P.; Jerz, G. Preparative Isolation and Purification of Flavonoids and Protocatechuic Acid from Sea Buckthorn Juice Concentrate (Hippophae rhamnoides L. ssp. rhamnoides) by High-Speed Counter-Current Chromatography. Chromatographia 2007, 65, 1–7. [Google Scholar] [CrossRef]
- Guazzaroni, M.; Crestini, C.; Saladino, R. Layer-by-Layer coated tyrosinase: An efficient and selective synthesis of catechols. Bioorg. Med. Chem. 2012, 20, 157–166. [Google Scholar] [CrossRef]
- Munro, B.; Vuong, Q.V.; Chalmers, A.C.; Goldsmith, C.D.; Bowyer, M.C.; Scarlett, C.J. Phytochemical, Antioxidant and Anti-Cancer Properties of Euphorbia tirucalli Methanolic and Aqueous Extracts. Antioxidants 2015, 4, 647–661. [Google Scholar] [CrossRef]
- Cirigliano, A.; Stirpe, A.; Menta, S.; Mori, M.; Dell’Edera, D.; Pick, E.; Negri, R.; Botta, B.; Rinaldi, T. Yeast as a tool to select inhibitors of the cullin deneddylating enzyme Csn5. J. Enzym. Inhib. Med. Chem. 2016, 31, 1632–1637. [Google Scholar] [CrossRef]
- Ottaviano, D.; Montanari, A.; De Angelis, L.; Santomartino, R.; Visca, A.; Brambilla, L.; Rinaldi, T.; Bello, C.; Reverberi, M.; Bianchi, M. Unsaturated fatty acids-dependent linkage between respiration and fermentation revealed by deletion of hypoxic regulatory KlMGA2 gene in the facultative anaerobe-respiratory yeast Kluyveromyces lactis. FEMS Yeast Res. 2015, 15, fov028. [Google Scholar] [CrossRef]
- Cirigliano, A.; Amelina, A.; Biferali, B.; Macone, A.; Mozzetta, C.; Bianchi, M.M.; Mori, M.; Botta, B.; Pick, E.; Negri, R.; et al. Statins interfere with the attachment of S. cerevisiae mtDNA to the inner mitochondrial membrane. J. Enzym. Inhib. Med. Chem. 2019, 35, 129–138. [Google Scholar] [CrossRef]
- Botta, L.; Filippi, S.; Zippilli, C.; Cesarini, S.; Bizzarri, B.M.; Cirigliano, A.; Rinaldi, T.; Paiardini, A.; Fiorucci, D.; Saladino, R.; et al. Artemisinin Derivatives with Antimelanoma Activity Show Inhibitory Effect against Human DNA Topoisomerase 1. ACS Med. Chem. Lett. 2020, 11, 1035–1040. [Google Scholar] [CrossRef]
- Cirigliano, A.; Macone, M.; Bianchi, M.M.; Oliaro Bosso, S.; Balliano, G.; Negri, R.; Rinaldi, T. Ergosterol reduction impairs mitochondrial DNA maintenance in S. cerevisiae. BBA Mol. Cell Biol. Lip. 2019, 1864, 290–303. [Google Scholar] [CrossRef]
- Ashraf, A.; Sarfraz, R.; Rashid, M.; Shahid, M. Antioxidant, antimicrobial, antitumor, and cytotoxic activities of an important medicinal plant (Euphorbia royleana) from Pakistan. J. Food Drug Anal. 2015, 23, 109–115. [Google Scholar] [CrossRef]
- Van Deenen, N.; Prufer, D.; Gronover, C. A latex lectin from Euphorbia trigona is a potent inhibitor of fungal growth. Biol. Plant. 2011, 55, 335–339. [Google Scholar] [CrossRef]
- Sadeghi-Aliabadi, H.; Sajjadi, S.; Khodamoradi, M. Cytotoxicity of Euphorbia macroclada on MDA-MB-468 breast cancer cell line. Iran. J. Pharm. Sci. 2009, 5, 103–108. [Google Scholar]
- Al-Faifi, Z.I.; Masrahi, Y.S.; Aly, M.S.; Al-Turki, T.A.; Dardeer, T. Evaluation of Cytotoxic and Genotoxic Effects of Euphorbia Triaculeata Forssk. Extract. Asian Pac. J. Cancer Prev. 2017, 18, 771–777. [Google Scholar] [CrossRef]
- Sarmiento-Salinas, F.L.; Delgado-Magallón, A.; Montes-Alvarado, J.B.; Ramírez-Ramírez, D.; Flores-Alonso, J.C.; Cortés-Hernández, P.; Reyes-Leyva, J.; Herrera-Camacho, I.; Anaya-Ruiz, M.; Pelayo, R.; et al. Breast Cancer Subtypes Present a Differential Production of Reactive Oxygen Species (ROS) and Susceptibility to Antioxidant Treatment. Front. Oncol. 2019, 9, 480. [Google Scholar] [CrossRef]
- Salimi, V.; Shahsavari, Z.; Safizadeh, B.; Hosseini, A.; Khademian, N.; Tavakoli-Yaraki, M. Sodium butyrate promotes apoptosis in breast cancer cells through reactive oxygen species (ROS) formation and mitochondrial impairment. Lipids Health Dis. 2017, 16, 208. [Google Scholar] [CrossRef]

Publisher’s Note: MDPI stays neutral with regard to jurisdictional claims in published maps and institutional affiliations. |
© 2022 by the authors. Licensee MDPI, Basel, Switzerland. This article is an open access article distributed under the terms and conditions of the Creative Commons Attribution (CC BY) license (https://creativecommons.org/licenses/by/4.0/).
Share and Cite
Ourhzif, E.-M.; Ricelli, A.; Stagni, V.; Cirigliano, A.; Rinaldi, T.; Bouissane, L.; Saso, L.; Chalard, P.; Troin, Y.; Khouili, M.; et al. Antifungal and Cytotoxic Activity of Diterpenes and Bisnorsesquiterpenoides from the Latex of Euphorbia resinifera Berg. Molecules 2022, 27, 5234. https://doi.org/10.3390/molecules27165234
Ourhzif E-M, Ricelli A, Stagni V, Cirigliano A, Rinaldi T, Bouissane L, Saso L, Chalard P, Troin Y, Khouili M, et al. Antifungal and Cytotoxic Activity of Diterpenes and Bisnorsesquiterpenoides from the Latex of Euphorbia resinifera Berg. Molecules. 2022; 27(16):5234. https://doi.org/10.3390/molecules27165234
Chicago/Turabian StyleOurhzif, El-Mahdi, Alessandra Ricelli, Venturina Stagni, Angela Cirigliano, Teresa Rinaldi, Latifa Bouissane, Luciano Saso, Pierre Chalard, Yves Troin, Mostafa Khouili, and et al. 2022. "Antifungal and Cytotoxic Activity of Diterpenes and Bisnorsesquiterpenoides from the Latex of Euphorbia resinifera Berg" Molecules 27, no. 16: 5234. https://doi.org/10.3390/molecules27165234
APA StyleOurhzif, E.-M., Ricelli, A., Stagni, V., Cirigliano, A., Rinaldi, T., Bouissane, L., Saso, L., Chalard, P., Troin, Y., Khouili, M., & Akssira, M. (2022). Antifungal and Cytotoxic Activity of Diterpenes and Bisnorsesquiterpenoides from the Latex of Euphorbia resinifera Berg. Molecules, 27(16), 5234. https://doi.org/10.3390/molecules27165234

